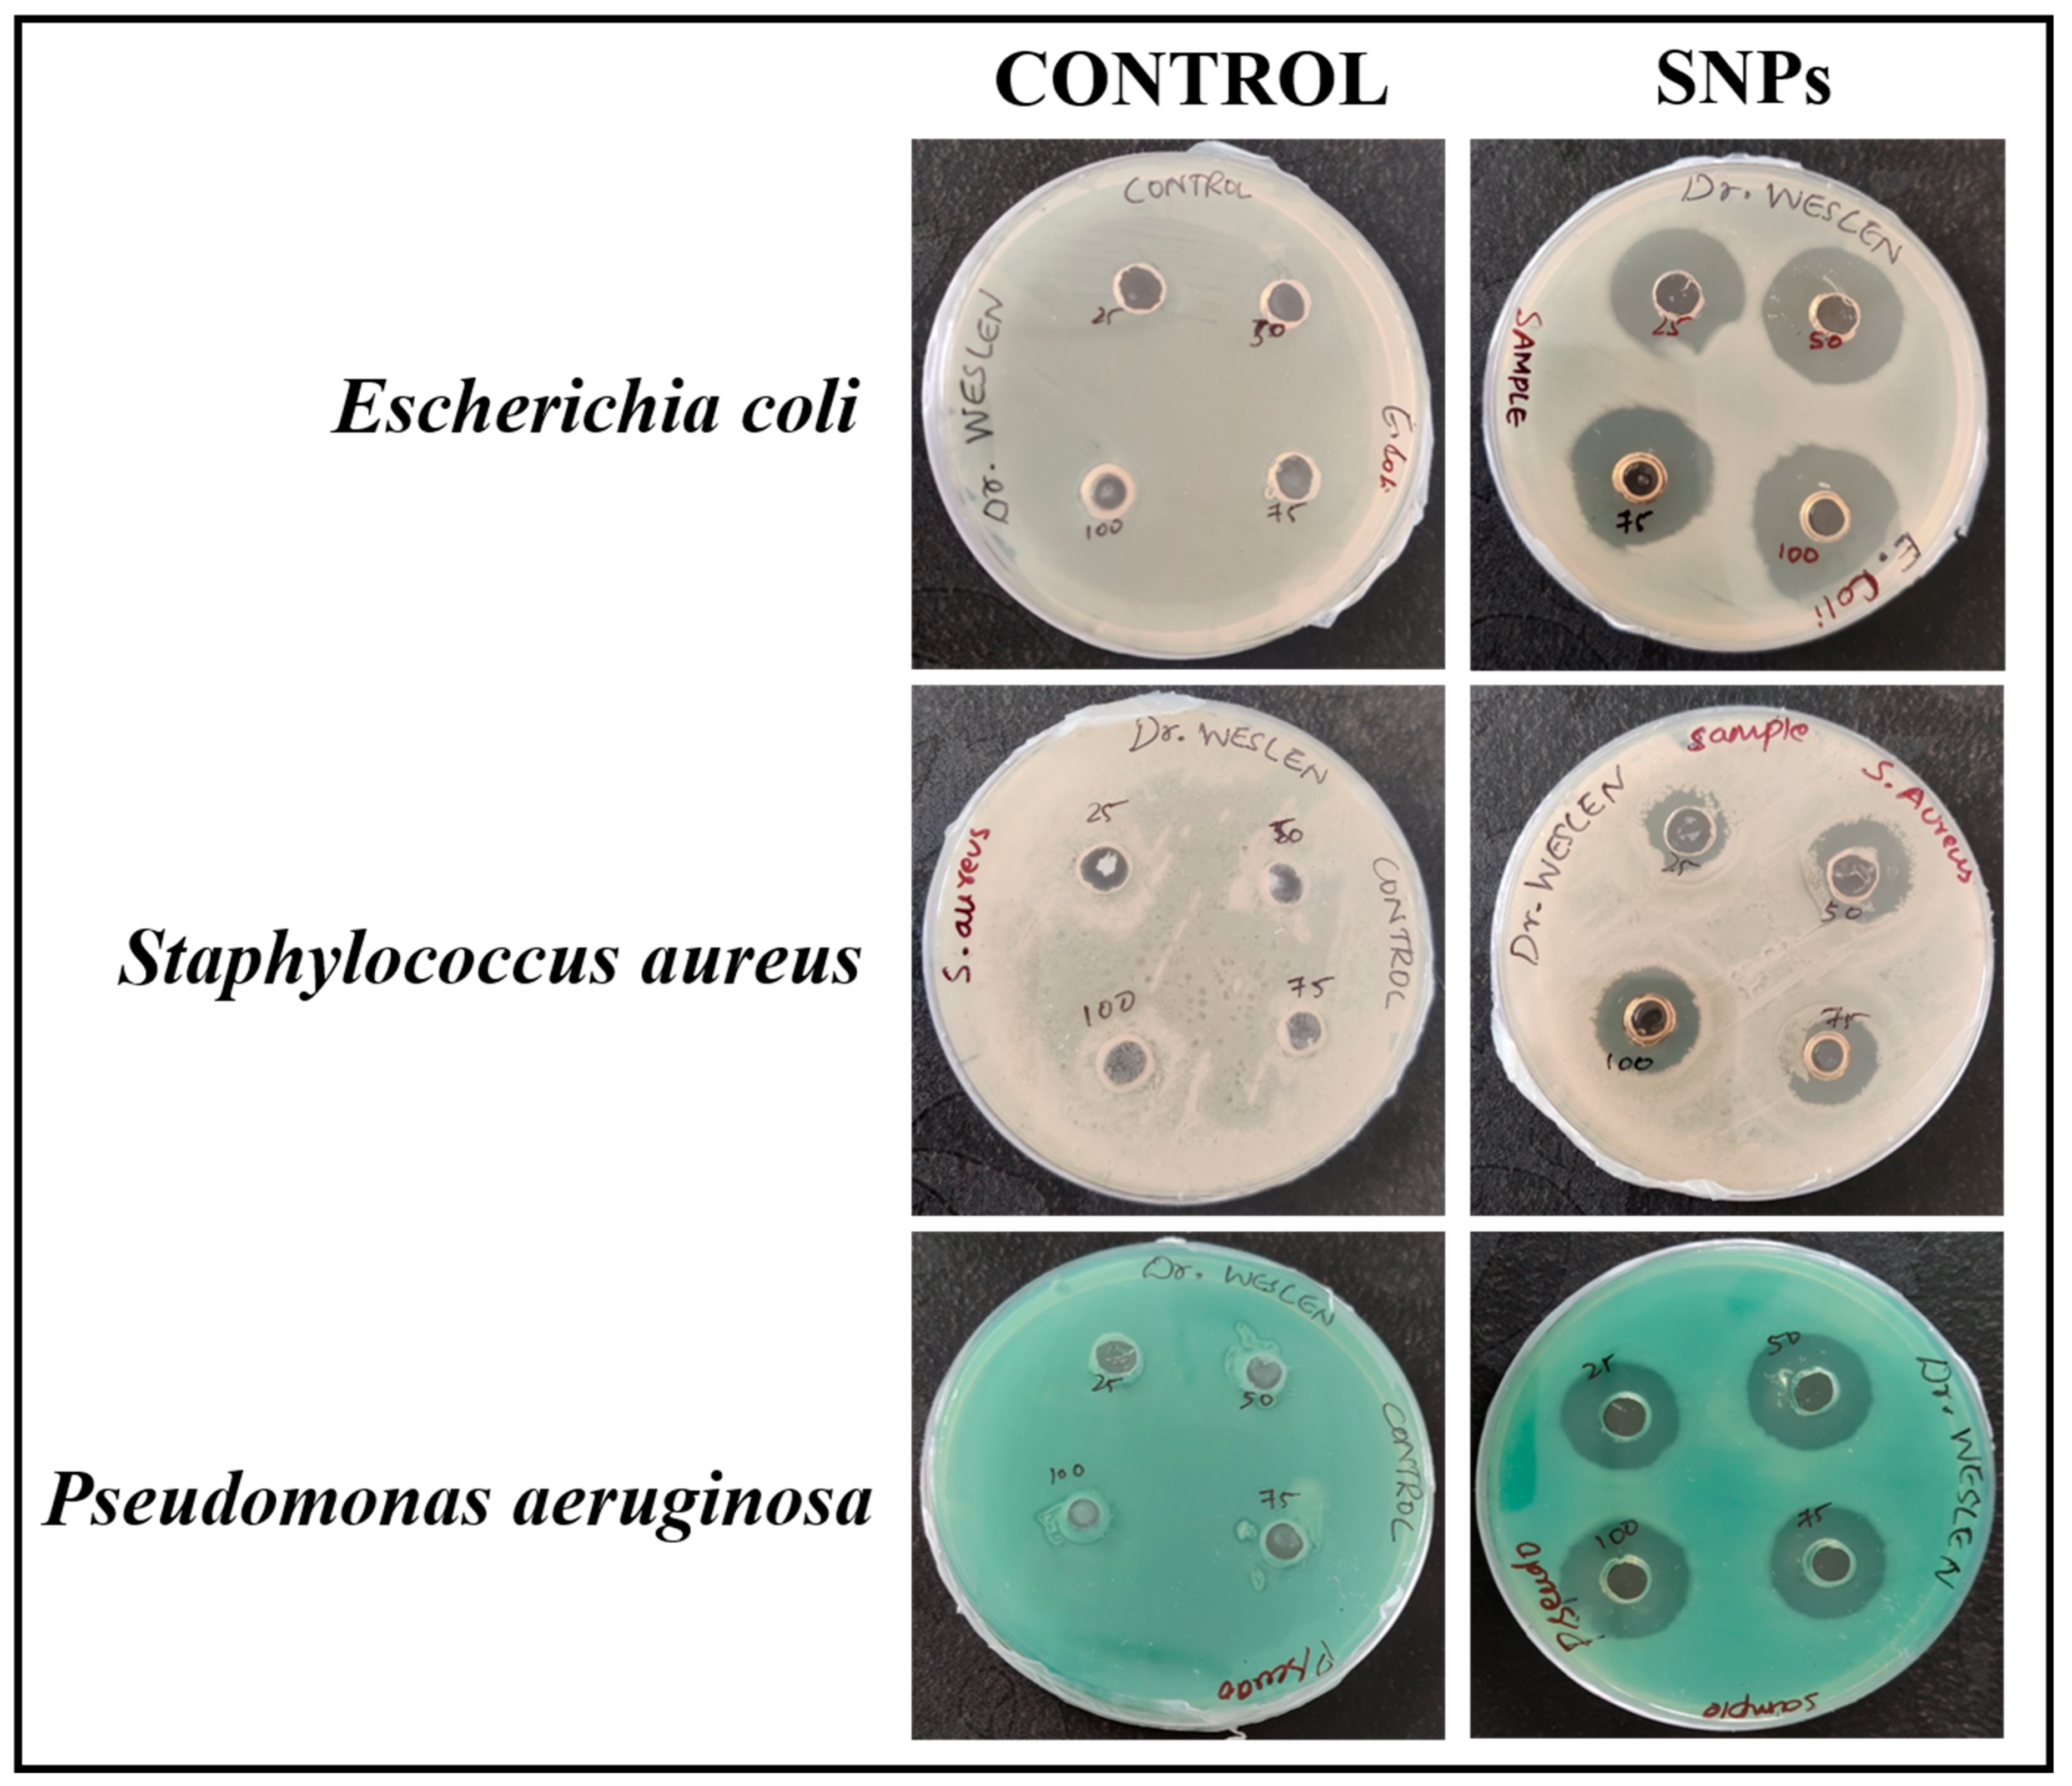
Chemosensors 11 00373 g010 Chemosensors 11 00373 g010

Abstract
Biogenic nanoparticles synthesized using medicinal plant extracts gain significant attention in the field of medicine. Current research reports about a simple, low cost, eco-friendly method to prepare silver nanoparticles (SNPs) using the leaf extract of Plectranthus amboinicus. UV-Visible spectroscopic analysis showed a surface plasmon resonance peak of synthesized SNPs at 410 nm. SNPs had an average hydrodynamic diameter of 111.5 nm with a zeta potential value of –19.4 mV. FTIR spectroscopic measurement revealed the characteristic peaks of SNPs. Electron microscopic analysis showed spherical-shaped nanoparticles. The potency of SNPs as a calorimetric biosensor was evaluated using its ability in detecting triethylamine (TEA)—a toxic organic solvent. A drastic change in color (pale yellow → dark black) was observed when an SNPs was treated with varying concentrations (0.01 to 0.3 mM) of TEA. SNPs showed antibacterial activity against Escherichia coli, Staphylococcus aureus, and Pseudomonas aeruginosa. Furthermore, the biosynthesized SNPs possessed efficient anticancer activity against B16F10 murine melanoma cells, which was evaluated using MTT, scratch wound, and live/dead cell assays. These results prove that SNPs can serve as biosensors and antibacterial and anticancer agents for industrial and biomedical applications.
1. Introduction
Colorimetric methods have drawn significant attention in the field of environmental pollutant testing due to their low cost and simplicity [1]. A sensor is a device that consists of a detecting tool and a signal transducer which aids in the generation of signals whose strength is equivalent to the concentration of the analyte. The sensors endure to have a great impact in biological and medical applications due to their great sensitivity, quick response, and inexpensive cost [2]. Colorimetric sensors have the option of detecting a specific compound in test samples through the naked eye by a change in color without the requirement of any sophisticated instruments. They have been widely used in environmental monitoring, medical diagnostics, and biosensing applications. In recent years, extensive research has focused on developing nanoparticle-based sensors that can be used to detect the presence of analytes via the naked eye detection method.
Nanomaterials are used in finding toxic environmental pollutants as their detection efficacy is highly significant [3]. The nanoscale dimension is the primary factor in the specificity of nanosensors in detecting pollutants or toxic compounds. When the surface-to-volume ratio increases, it leads to effective adsorption of toxic compounds, thereby making nanomaterials suitable candidates for the sensing of harmful substances. Silver nanoparticles (SNPs) provide tremendous opportunity to researchers by modifying and functionalizing their structure and surface in order to improve their efficacy. They are ideal candidates for environmental monitoring and colorimetric sensing applications. SNPs are widely used as calorimetric sensors as their photonic behavior can be altered through aggregation process, resulting in a change of the yellow color of SNPs. Thus, SNPs are used as suitable visual sensors for detection of different types of analytes [4]. Abdel-Lateef et al. prepared PVP-capped silver nanoparticles using a microwave-assisted heating method. The size of the nanoparticles was less than 10 nm, which aided in providing peroxidase-mimicking activity [5]. This efficacy was used to catalytically oxidize colorless O-phenylenediamine into greenish yellow 2,3-diaminophenazine in the presence of hydrogen peroxide. This potency was reduced in the presence of Hg2+ ions, which were employed to detect Hg2+ ions in aqueous systems using the naked eye and spectrophotometry [5]. Bastami et al. prepared silver citrate-coated Au@Ag nanoparticles and demonstrated their ability in detecting morphine using the naked eye and using the change in color from light yellow to brown [6].
Triethylamine (TEA) is an important industrial chemical compound which is colorless and possess a strong, fishy, pungent malodor. It is used as a surfactant, catalyst, polar solvent, and an intermediate in manufacturing fertilizers. TEA and its vapors are toxic, explosive, and flammable [7,8]. It acts as an irritant to the respiratory tract causing headaches, chemical burns, pulmonary edema, and even death. According to the National Institute for Occupational Safety and Health (NIOSH), the concentration of TEA in a safe working environment should be less than 10 ppm (parts per million) [9]. TEA is also discharged into the ecosystem via decaying marine wastes [3]. Thus, it is imperative to develop a sensor that can detect TEA with high sensitivity and selectivity [10]. There have been several developments in TEA gas sensors, including metal oxide semiconductor, optical, and cataluminescence sensors. Metal oxide semiconductor-based gas sensors are an interesting option for TEA monitoring due to their advantages of low cost, simple fabrication, and quick detection [11]. A quick colorimetric TEA sensor was created by Filippo et al. which employs the surface plasmon resonance (SPR) of SNPs in detecting TEA [10]. In recent years, the development of visual colorimetric sensors has gained a lot of attention due to their ease, speed, and ability in detecting compounds using the naked eye, without the need for sophisticated instruments.
The field of nanotechnology is a fast-emerging scientific technology that involves the development and fabrication of novel materials for various applications such as electronics, sensors, medicine, and agriculture [12,13,14,15,16,17,18,19,20]. The physical characteristics of noble metal nanoparticles have been extensively explored by many scientists for the past few decades for various biomedical applications [21]. Noble metal nanoparticles such as silver and gold have drawn the attention of scientific researchers owing to their attractive applications in the areas of materials science, medicine, biology, and the food packaging industry [22,23]. Silver nanoparticles are used in various fields for producing valuable products for the use of mankind [24]. They are widely used in the field of medicine due to their versatile properties and physiochemical characteristics [25]. The three most commonly used approaches for synthesizing nanoparticles are physical, chemical, and biological methods. The disadvantages of using physical and chemical methods are listed below: (i) the physical method is time-consuming, costly, and requires special necessities like high temperature and pressure, and (ii) the chemical method employs the use of materials including 2-mercaptoethanol, borohydride, citrate, and thioglycerol which are toxic when discharged into the environment. To overcome this problem, the biosynthesis of nanoparticles using plant extract can be used as an alternative as it is a safe, low cost, and environment friendly method [26,27]. Due to their significant characteristics such as antibacterial, antifungal, antiviral, anti-inflammatory, anticancer, and antiplatelet, SNPs are widely used in the field for biomedical applications [19,28]. The synthesis of silver nanoparticles using the green synthesis method has earned immense attention in the field of medicine [29,30].
The Plectranthus amboinicus (Loureiro) Sprengel, also called Indian borage, belong to the family member “Lamiaceae”. It is a tender, fleshy perennial herb found in regions of Asia, Australia, and Africa. The plant leaves have potent medicinal characteristics which are mainly due to the presence of phytochemical substances. The plant leaf has an oregano-like flavor and odor and also exhibits antimicrobial, anticancer, anti-inflammatory, and antioxidant properties [31,32,33]. Plectranthus amboinicus is a medicinal plant used in treating various diseases such as cardiovascular, skin, respiratory, urinary, and digestive disorders. Various techniques such as microemulsion, photochemical reduction, chemical reduction, green synthesis, etc., are employed for the preparation of SNPs [25]. Among these methods, green synthesis using plants, microbes, or fungi are widely accepted due to their eco-friendly property. However, plant sources are commonly used in synthesizing SNPs due to the lack of chemical or bacterial contamination and presence of different functional compounds such as terpenoids, phenols, flavones, etc. [34,35].
Antibiotic resistance is a serious issue faced by the health sector in recent years [36]. Nanoparticles have been demonstrated to be a promising candidate with potent antimicrobial activity, as their large surface-to-volume ratio helps in evading bacteria. SNPs serve as effective antimicrobial agents against both bacteria (gram-positive and gram-negative). Several investigations have demonstrated that the silver ions generated by SNPs can adhere to the bacterial cell wall, induce cell damage, and eventually result in cell death [37]. Green synthesized SNPs are used to overcome antibiotic resistance as they possess a broad spectrum of anti-microbial activity against different types of bacteria and fungi. When compared with the different types of nanoparticles such as iron, gold, zinc, and platinum, SNPs shows excellent anti-bacterial activity when utilized individually or in combination with anti-bacterial drugs. They have the capacity to modify the cell wall and cell membrane of microbes, trigger the synthesis of reactive oxygen species, and aid in cell death via apoptosis or necrosis. SNPs are also used in disease diagnosis, wound treatment, dental implants, and the food and textile industries due to their tremendous anti-microbial activity [38]. SNPs have proved to hold effective anti-cancer properties and aid in reducing the progressive development of cancer cells. The reason behind the anti-cancer activity may be due to their ability of SNPs in inhibiting various signaling pathways that are responsible for progression of cancer. Several reports have demonstrated the cytotoxic effect of SNPs against cancer cells without affecting the normal cells [34].
In the present work, SNPs were prepared using the leaf extract of Plectranthus amboinicus. The detection of triethylamine using SNPs was analyzed using simple visual sensing approach. The concentration of TEA used for the study ranges from 0.01 mM to 0.3 mM. Antibacterial activity of SNPs using Escherichia coli, Pseudomonas aeruginosa, and Staphylococcus aureus were also investigated. In addition, scratch wound healing and live-death cell assays were performed using murine melanoma cancer cell line (B16F10) to study the anticancer effect of SNPs.
2. Materials and Methods
Silver nitrate, triethylamine, MTT (3-[4,5-dimethylthiazol-2-yl]-2,5-diphenyltetrazolium bromide), dimethyl sulfoxide, acridine orange, ethidium bromide, Dulbecco’s Modified Eagle Medium (DMEM), fetal bovine serum (FBS), trypsin-EDTA (ethylenediaminetetraacetic acid) solution, antibiotic-antimycotic solution, nutrient broth, and nutrient agar were procured from HiMedia Laboratories Pvt. Ltd., Maharashtra, India. B16F10 murine melanoma cell lines were procured from NCCS, India. Escherichia coli, Staphylococcus aureus, and Pseudomonas aeruginosa were procured from CSIR-IMTECH, India.
2.1. Extraction of Plant Leaves Extract
Fresh leaves of Plectranthus amboinicus were obtained from Chettinad Garden, Kelambakkam. A total of 10 g of fresh leaves were cleaned using deionized water to eliminate impurities and dust particles. Plectranthus amboinicus leaves were minced into small pieces. They were soaked in 50 mL of deionized water. The contents were allowed to boil at 60 °C for 30 min. The solution contents were subjected to centrifugation for 10 min at 4000 rpm. The plant extract was kept at 4 °C until it was utilized for further experiments (Figure 1).

Figure 1.
Extraction of Plectranthus amboinicus leaf extract.
2.2. Synthesis of Silver Nanoparticles (SNPs)
A simple and rapid method was employed for synthesizing SNPs using the plant extract of Plectranthus amboinicus. Briefly, 100 mL of 1 mM of silver nitrate solution was prepared and stirred at 500 rpm at 80 °C for 15 min. To this, a few drops of plant extract was added until the color changed to pale yellow which indicated the formation of SNPs (Figure 2). The solution was centrifuged at 10,000 rpm and the pellet obtained was subjected to ethanol wash two times. The sample was dried and used for further characterization.

Figure 2.
Synthesis of SNPs using Plectranthus amboinicus leaf extract.
2.3. Characterization
UV-Visible spectroscopic analysis of SNPs was analyzed using UV-1800 Shimadzu UV-Visible spectrophotometer with a wavelength range from 200 to 800 nm and resolution of 1 nm. FTIR spectroscopic analysis was carried out using Bruker Alpha FTIR spectrophotometer. A few milligrams of SNPs were grounded with potassium bromide and shaped as a round pellet using a hydraulic press. The pellet prepared was used to record the FTIR spectrum of SNPs. Zetasizer Nanoseries s90 was used for analyzing average particle size and surface charge of SNPs. JASCO FP-8300 Fluorescence Spectrophotometer was used to study the photoluminescence property of SNPs. JEM 2100Plus electron microscope with an accelerating voltage of 200 kV was used to study the size of SNPs.
2.4. Detection of Triethylamine (TEA) using Silver Nanoparticles (SNPs)
The efficacy of SNPs to be used as a colorimetric sensor for detection of different concentrations of TEA was studied using a simple method with 0.01 mM to 0.3 mM of TEA, where pure SNPs without any treatment was used as a control. For this experiment, an equal concentration of SNPs was added to the different dilutions of TEA to determine the presence of TEA. Various concentrations of TEA used for the experiment are given in Table 1.

Table 1.
Various concentrations of TEA used for the experiment.
2.5. In Vitro Studies
2.5.1. Antimicrobial Activity
The antimicrobial property of SNPs was investigated against three different microorganisms such as Escherichia coli, Staphylococcus aureus, and Pseudomonas aeruginosa. For this experiment, 25, 50, 75, and 100 μg/well of SNPs were used to estimate the antibacterial activity. The aforementioned microorganisms (1 × 106 CFU) were grown overnight in nutrient broth. In nutrient agar plates, 100 μL of bacterial culture was spread uniformly using a sterile L-Rod. The agar plates were punctured using a gel puncture to create wells. PBS solution was used as a control. Different concentrations of SNPs were added to respective wells and the plates were kept at 37 °C for one day. After incubation, the zone of inhibition formed after SNPs treatment was photographed for determining the antibacterial activity of the prepared SNPs.
2.5.2. Anticancer Activity
MTT Assay
The anticancer efficacy of SNPs was determined by performing an MTT assay using B16F10 cells. Briefly, cells were seeded in 96 well plates and incubated in a CO2 incubator for one day. The cells were incubated with various concentrations of SNPs and control cells did not receive any treatment. After 24 h of incubation, MTT was added to the cells and incubated for 4 h. Further, dimethyl sulfoxide was used for dissolving formazan crystals. The IC50 value was obtained by quantifying the optical density at 570 nm.
Scratch Wound Assay
The migration of B16F10 melanoma cells in the presence of SNPs was studied using the scratch wound assay. For this assay, cells were grown on 6 well plates. They were allowed to grow until 90% confluency was reached. With the help of sterile micropipette tips, a wound was created. The cells were then washed twice with sterile phosphate buffered saline (PBS) to remove the debris and dead cells. The SNPs were added to each well and photographs were taken at different time periods (0 h and 24 h) to determine the anticancer effect of SNPs on melanoma cell lines.
Live/Dead Cell Assay
A live/dead cell assay was carried out to determine the number of viable cells in the presence of SNPs. For this assay, two fluorescent dyes—acridine orange and ethidium bromide—were used to detect live and dead cells. B16F10 cells were grown in a 6 well plate until 90% confluency was reached. The cells were incubated with 50 µg/mL of SNPs for 24 h. After incubation for 24 h, acridine orange/ethidium bromide staining solution was added to treated wells. Photographs were taken using fluorescent microscopy.
3. Results and Discussion
Noble metal nanoparticles are widely synthesized using different types of chemical and physical methods which are not environmentally friendly. Thus, it is necessary to develop a safe and eco-friendly method for synthesizing nanoparticles. For the past few years, the scalable green synthesis method, which employs biological systems such as microbes or plant extract, is used to synthesize nanoparticles owing to its rapid, inexpensive, and environmentally friendly and reproducible properties [39,40]. The biomolecules present in the extract not only reduce the metal ions but also serve as capping agents and aid in reducing aggregation of nanoparticles. In addition, they also impart beneficial properties and improve the bioactivity of prepared nanoparticles. Green synthesized nanoparticles are used in multiple areas such as cancer treatment, gene delivery, biosensing, imaging, drug delivery, etc. [41]. In the present study, the phytoreduction method was employed to synthesize SNPs using the leaf extract of Plectranthus amboinicus. Formation of SNPs was determined using the change in color of silver nitrate solution to pale yellow. Plectranthus amboinicus extract served as a reducing and capping agent.
3.1. Characterization
UV-Visible spectrophotometer was used to measure the absorbance of synthesized nanoparticles. Figure 3a,b show the UV-Visible absorption spectra of Plectranthus amboinicus extract and SNPs, respectively. SNPs showed maximum UV absorption at 410 nm which indicates the formation of SNPs. This corresponds to the surface plasmon resonance (SPR) of the SNP. The SPR patterns are widely used to detect the formation of metal nanoparticles [42]. Figure 3c shows UV-Visible spectra of SNPs at different time intervals (10 min, 20 min, 30 min, 40 min, 50 min, 60 min, and 70 min). When the reaction time was increased, a slight elevation in the absorbance intensity of SNPs was observed.

Figure 3.
UV-Visible spectroscopic analysis of (a) plant extract, (b) SNPs, and (c) SNPs at different time intervals (10, 20, 30, 40, 50, 60, and 70 min).
Fourier transform infrared (FTIR) spectroscopic measurements were performed to study the functional groups present in the prepared SNPs and Plectranthus amboinicus extract. Figure 4a demonstrates the FTIR spectra of SNPs and their interaction between the biomolecules of leaf extract. The absorption band at 1620 cm−1 of plant extract corresponds to the stretching vibration of the C=C group. The band at 1332 cm−1 may be due to the presence of C-N-like amine or C-O-like phenol groups. The band at 1078 cm−1 is due to the presence of C-N (aliphatic amine) stretching vibration. The FTIR spectrum of SNPs showed a similar result as that of the plant extract. However, the peaks at 1393 cm−1 and 828 cm−1 correspond to the C–N stretching vibrations and out-of-plane bending vibrations of the –O-H groups, respectively [43]. Dynamic light scattering (DLS) is a method which is widely used to study the hydrodynamic particle size distribution, zeta potential, and polydispersity index (PDI) of the nanoparticles. In the present study, DLS was used to determine the above-mentioned properties of synthesized SNPs. Figure 4b shows the size of the SNPs at 111.5 nm with a low PDI value of 0.104. Figure 4c shows the zeta potential value of SNPs as −19.4 mV. Noble metals have an excellent photoluminescent property and their luminescence can be studied by irradiating their surface using electrons, laser beams, or photons. Several studies have reported the photoluminescence property of green synthesized silver nanoparticles. Thus, in the present study, the photoluminescence spectrum of SNPs was recorded by exciting the samples at a wavelength of 300 nm. Figure 5 shows the photoluminescence emission spectrum of SNPs with a strong and well-defined peak at around 378 nm. Transmission electron microscopy was employed to determine the morphology of the SNPs which showed spherical-shaped nanoparticles with sizes less than 50 nm (Figure 6).

Figure 4.
(a) FTIR spectra of SNPs and Plectranthus amboinicus leaf extract. (b) DLS measurement of SNPs. (c) Zeta potential measurement of SNPs.

Figure 5.
Photoluminescence spectrum of SNPs.

Figure 6.
TEM images of SNPs at different magnification.
3.2. Visual Sensing of TEA
The efficacy of prepared SNPs as a potent colorimetric sensor was studied using different concentrations of TEA. Various concentrations of TEA (0.01 mM to 0.3 mM) were added to SNPs and the color change from pale yellow to dark black was witnessed using the naked eye (Figure 7). Shobana et al. prepared SNPs using Sapindus mukorossi to detect TEA at various concentrations (1 mM, 2 mM, 3 mM, 5 mM, 7 mM, and 10 mM) which exhibited color changes from pale yellow to dark yellow, dark brown, and dark green [3]. Self-aggregation of the nanoparticles may be the possible reason for change in color. Additional experiments must be carried out to study the exact mechanism behind the change in color of SNPs in the presence of TEA. Based upon the result obtained, it is evident that the prepared SNPs can be used to determine the presence of TEA even at lower concentrations such as 0.01 mM. UV-Visible spectroscopy was performed after incubating with TEA for 0 min, 15 min, 30 min, 45 min, and 60 min, respectively, to study any change in the UV absorption of SNPs in the presence of TEA (Figure 8). When the concentration of TEA was increased, there was a shift in the UV absorption of the SNPs, with the change in peak intensity. A similar outcome was observed with the silver nanoparticles prepared by Shobana [3] and Filippo et al. [10]. Figure 9 shows the transmission electron microscopic images of the SNPs after addition of 0.3 mM TEA.

Figure 7.
Visual sensing of different concentrations of TEA using SNPs.

Figure 8.
(a–e) UV-Visible spectroscopic analysis of SNPs at different time intervals (0 min, 15 min, 30 min, 45 min, and 60 min) in the presence of different concentrations of TEA (0.01 mM to 0.3 mM).

Figure 9.
TEM images of SNPs in the presence of 0.3 mM of TEA.
3.3. In Vitro Studies
3.3.1. Antimicrobial Activity
The agar well diffusion method is a widely accepted technique for determining the antimicrobial property of the green synthesized nanoparticles against gram-positive and gram-negative bacteria. As shown in Figure 10, PBS did not have any antibacterial activity against any of the test microorganisms—Escherichia coli, Staphylococcus aureus, and Pseudomonas aeruginosa—whereas SNPs showed antibacterial activity which was evidenced by the formation of zone of inhibition formed around the wells treated with SNPs. The potent antibacterial efficacy of SNPs against Escherichia coli when compared with Staphylococcus aureus and Pseudomonas aeruginosa may be due to the variation in gram-positive and gram-negative bacteria cell wall. The gram-positive bacterial cell wall is made up of a dense layer of peptidoglycan, which is composed of linear polysaccharide chains that are cross-linked by short peptides, whereas the gram-negative bacterial cell wall is made up of a thin layer of peptidoglycan [44] which could be the possible explanation behind the potent antibacterial efficacy of SNPs against Escherichia coli. Few research reports have stated that SNPs have the ability to generate reactive oxygen species (ROS), followed by the release of Ag+ ions from SNPs which may denaturize proteins by interacting with sulfhydryl groups, and the adherence of SNPs to bacteria may cause deterioration of the bacterial cell wall [28]. Hemlatha et al. prepared SNPs using Cucumis prophetarum, which formed a zone of inhibition of 18 mm against Pseudomonas aeruginosa [44]. Khan et al. prepared SNPs using Juniperus procera extract and studied their antibacterial activity against Escherichia coli, Staphylococcus aureus, and Pseudomonas aeruginosa, respectively [45]. From the results obtained, it is evident that the prepared SNPs shows antibacterial activity against Escherichia coli, Staphylococcus aureus, and Pseudomonas aeruginosa, respectively. Increased concentration of SNPs did not show any significant change in the antibacterial efficacy against Escherichia coli and Pseudomonas aeruginosa.

Figure 10.
Antimicrobial activity of SNPs against Escherichia coli, Staphylococcus aureus, and Pseudomonas aeruginosa.
3.3.2. Anticancer Activity
MTT Assay
The anticancer activity of green synthesized SNPs was studied using B16F10 melanoma cells. The results obtained using an MTT assay revealed that the prepared SNPs decreased the survival of B16F10 cells in a dose-dependent manner, with an IC50 value of 42 μg/mL (Figure 11). At this concentration, SNPs inhibited 50% of cell viability after 24 h of incubation. Gomathi et al. proved that biosynthesized SNPs showed excellent anticancer activity against MCF-7 cancer cells with an IC50 value of 20 μg/mL [34].

Figure 11.
MTT Assay for different concentrations of SNPs.
Scratch Wound Healing
Further, the scratch wound assay was used to study the anti-proliferative effect of the prepared SNPs. Noorbazargan et al. prepared SNPs using Juniperus chinensis extract and a scratch wound assay was performed using A459 lung cancer cells. SNPs have the ability to generate reactive oxygen species and lead to oxidative stress, which in turn could activate the apoptotic pathway and cause cell death in cancer cells [46]. Khan et al. showed a significant reduction in the migration of MCF-7 cells when incubated with biogenic SNPs at a concentration of 2 µg/mL. In the present study, B16F10 cells were treated with 20 μg/mL of prepared SNPs [47]. Photographs were taken at 0 h and 24 h after incubating with SNPs. The control group did not have any treatment. In Figure 12, the anticancer activity of SNPs is evidenced by its ability in inhibiting the cell migration potency of the cancer cells. Initially (up to 12 h), control and SNPs treated groups did not show any significant changes in the cell migration (picture is not shown), but after 24 h complete wound closure was seen in untreated control, whereas the SNPs treated group took more time for complete healing of scratch wounds. These results proved that the synthesized SNPs can efficiently inhibit the migration of B16F10 cells.

Figure 12.
Scratch wound assay of SNPs treated B16F10 melanoma cells.
Live/Dead Cell Assay
A live/dead cell assay was carried out using a combination of two different dyes—acridine orange and ethidium bromide (AO/EtBr). After treating with SNPs, the cells were stained with AO/EtBr and viewed under the fluorescence microscope to view the live and dead cells. Gomathi et al. prepared SNPs using Tamarindus indica and studied their anticancer activity by performing a live/dead cell assay using MCF-7 human breast cancer cells [34]. When cells are treated with a combination of AO/EtBr, dead cells will take up EtBr due to the loss of their membrane integrity and appear red, whereas live cells will be stained using AO and appear green under a fluorescent microscope. Cells in the late apoptotic phase will appear orange in color due to condensed and fragmented chromatin [48]. Figure 13 shows the microscopic fluorescent images of B16F10 melanoma cells after SNPs treatment. The results show that SNPs treatment results in the increase of red and orange cells with a significant reduction in the number of live or green cells. The result proves the anticancer effect of SNPs. Further investigations must be carried out to determine the mechanism by which SNPs execute potential anticancer activity.

Figure 13.
(a,b) Live/dead cell assay for SNPs treated B16F10 melanoma cell lines.
4. Conclusions
Green synthesized SNPs are widely accepted due to their cost-effective, antimicrobial, and eco-friendly nature. Various types of biomolecules such as phenols, alkaloids, terpenes, tannins, etc., present in the plant extract serve as reducing, stabilizing, and capping agents during the process of preparation of SNPs. In the present work, SNPs were green synthesized using Plectranthus amboinicus and their efficacy as a sensor for TEA was studied. The synthesized SNPs had maximum UV absorption at 410 nm with a spherical shape under transmission electron microscopy. The detection of TEA was studied using different concentrations ranging from 0.01 mM to 0.3 mM. The addition of TEA to SNPs resulted in a color change from pale yellow to dark black. SNPs showed efficient antibacterial activity against Escherichia coli, Staphylococcus aureus, and Pseudomonas aeruginosa. An MTT assay revealed the anticancer activity of prepared SNPs against B16F10 murine melanoma cells. A scratch wound assay showed the ability of SNPs in inhibiting the migration of B16F10 cells. Thus, the prepared SNPs could be used as a sensor and anti-bacterial and anti-cancer agent for various applications.
Author Contributions
Investigation, methodology, writing—original draft, L.P.; Conceptualization, investigation, writing—review and editing and supervision, W.V.S.; Formal analysis and investigation, B.V.Y. and G.K.S.; Investigation and visualization, R.A. All authors have read and agreed to the published version of the manuscript.
Funding
The authors Weslen Vedakumari Sathyaraj and Lokesh Prabakaran thank the Science and Engineering Research Board (SERB), Government of India for supporting this work under the Promoting Opportunities for Women in Exploratory Research (SERB-POWER) Scheme [File Number: SPG/2021/003353].
Institutional Review Board Statement
Not applicable.
Informed Consent Statement
Not applicable.
Data Availability Statement
Not applicable.
Acknowledgments
Special thanks are given to Jayavardhini Bhoopathy from the Faculty of Allied Health Sciences at Chettinad Hospital and Research Institute for her kind assistance in formal analysis of the article.
Conflicts of Interest
The authors declare no conflict of interest.
References
- Alberti, G.; Zanoni, C.; Magnaghi, L.R.; Biesuz, R. Disposable and Low-Cost Colorimetric Sensors for Environmental Analysis. Int. J. Environ. Res. Public Health 2020, 17, 8331. [Google Scholar] [CrossRef] [PubMed]
- Sumitha, M.S.; Xavier, T.S. Recent Advances in Electrochemical Biosensors—A Brief Review. Hybrid Adv. 2023, 2, 100023. [Google Scholar] [CrossRef]
- Shobana, J.; Kalaivani, D.; Porchezhiyan, V.; Noorjahan, S.E. Visual Sensing of Triethyl Amine Using Sapindus Mukorossi—Silver Nanoparticles. Mater. Today Proc. 2022, 60, 1257–1260. [Google Scholar] [CrossRef]
- Prosposito, P.; Burratti, L.; Venditti, I. Silver Nanoparticles as Colorimetric Sensors for Water Pollutants. Chemosensors 2020, 8, 26. [Google Scholar] [CrossRef]
- Abdel-Lateef, M.A.; Almahri, A.; Alzahrani, E.; Pashameah, R.A.; Abu-Hassan, A.A.; El Hamd, M.A. Sustainable PVP-Capped Silver Nanoparticles as a Free-Standing Nanozyme Sensor for Visual and Spectrophotometric Detection of Hg2+ in Water Samples: A Green Analytical Method. Chemosensors 2022, 10, 358. [Google Scholar] [CrossRef]
- Rohani Bastami, T.; Bayat, M.; Paolesse, R. Naked-Eye Detection of Morphine by Au@Ag Nanoparticles-Based Colorimetric Chemosensors. Sensors 2022, 22, 2072. [Google Scholar] [CrossRef]
- Bi, Y.; Zhao, Y.; Meng, X.; Cong, H.; Gao, W. Synthesis of Ag-Functionalized α-Fe2O3 Nanocomposites for Ppb-Level Triethylamine Detection. J. Alloys Compd. 2022, 913, 165264. [Google Scholar] [CrossRef]
- Meng, F.; Liao, Z.; Xing, C.; Yuan, Z.; Zhang, R.; Zhu, H.; Li, J. Preparation of SnO2/SiO2 Nanocomposites by Sol-Gel Method for Enhancing the Gas Sensing Performance to Triethylamine. J. Alloys Compd. 2022, 893, 162189. [Google Scholar] [CrossRef]
- Yan, Y.; Liu, J.; Liu, Q.; Yu, J.; Chen, R.; Zhang, H.; Song, D.; Yang, P.; Zhang, M.; Wang, J. Ag-Modified Hexagonal Nanoflakes-Textured Hollow Octahedron Zn2SnO4 with Enhanced Sensing Properties for Triethylamine. J. Alloys Compd. 2020, 823, 153724. [Google Scholar] [CrossRef]
- Filippo, E.; Manno, D.; Buccolieri, A.; Serra, A. Green Synthesis of Sucralose-Capped Silver Nanoparticles for Fast Colorimetric Triethylamine Detection. Sens. Actuators B Chem. 2013, 178, 1–9. [Google Scholar] [CrossRef]
- Han, Y.; Liu, Y.; Su, C.; Chen, X.; Zeng, M.; Hu, N.; Su, Y.; Zhou, Z.; Wei, H.; Yang, Z. Sonochemical Synthesis of Hierarchical WO3 Flower-like Spheres for Highly Efficient Triethylamine Detection. Sens. Actuators B Chem. 2020, 306, 127536. [Google Scholar] [CrossRef]
- Vankudoth, S.; Dharavath, S.; Veera, S.; Maduru, N.; Chada, R.; Chirumamilla, P.; Gopu, C.; Taduri, S. Green Synthesis, Characterization, Photoluminescence and Biological Studies of Silver Nanoparticles from the Leaf Extract of Muntingia Calabura. Biochem. Biophys. Res. Commun. 2022, 630, 143–150. [Google Scholar] [CrossRef]
- Payal; Pandey, P. Role of Nanotechnology in Electronics: A Review of Recent Developments and Patents. Recent Pat. Nanotechnol. 2022, 16, 45–66. [Google Scholar] [CrossRef] [PubMed]
- Ramesh, M.; Janani, R.; Deepa, C.; Rajeshkumar, L. Nanotechnology-Enabled Biosensors: A Review of Fundamentals, Design Principles, Materials, and Applications. Biosensors 2022, 13, 40. [Google Scholar] [CrossRef]
- Chauhan, S.; Tirkey, A.; Upadhyay, L.S.B. Nanomaterials in Biomedicine: Synthesis and Applications. In Advances in Nanotechnology-Based Drug Delivery Systems; Elsevier: Amsterdam, The Netherlands, 2022; pp. 585–604. [Google Scholar]
- Ghouse, H.; Slewa, L.; Mahmood, M.; Rehmat, S.; Musharrat, S.; Dahman, Y. Importance of Nanotechnology, Various Applications in Electronic Field. In Materials Horizons: From Nature to Nanomaterials; Springer: Berlin/Heidelberg, Germany, 2022; pp. 1–28. [Google Scholar]
- Kumar, H.; Kuča, K.; Bhatia, S.K.; Saini, K.; Kaushal, A.; Verma, R.; Bhalla, T.C.; Kumar, D. Applications of Nanotechnology in Sensor-Based Detection of Foodborne Pathogens. Sensors 2020, 20, 1966. [Google Scholar] [CrossRef] [PubMed]
- Prajapati, S.; Padhan, B.; Amulyasai, B.; Sarkar, A. Nanotechnology-Based Sensors. In Biopolymer-Based Formulations; Elsevier: Amsterdam, The Netherlands, 2020; pp. 237–262. [Google Scholar]
- Sakthi Devi, R.; Girigoswami, A.; Siddharth, M.; Girigoswami, K. Applications of Gold and Silver Nanoparticles in Theranostics. Appl. Biochem. Biotechnol. 2022, 194, 4187–4219. [Google Scholar] [CrossRef]
- Monisha, K.; Antinate Shilpa, S.; Anandan, B.; Hikku, G.S. Ethanolic Curcumin/Silver Nanoparticles Suspension as Antibacterial Coating Mixture for Gutta-Percha and Cotton Fabric. Eng. Res. Express 2023, 5, 025054. [Google Scholar] [CrossRef]
- Habibullah, G.; Viktorova, J.; Ruml, T. Current Strategies for Noble Metal Nanoparticle Synthesis. Nanoscale Res. Lett. 2021, 16, 47. [Google Scholar] [CrossRef]
- Yaqoob, A.A.; Ahmad, H.; Parveen, T.; Ahmad, A.; Oves, M.; Ismail, I.M.I.; Qari, H.A.; Umar, K.; Mohamad Ibrahim, M.N. Recent Advances in Metal Decorated Nanomaterials and Their Various Biological Applications: A Review. Front. Chem. 2020, 8, 341. [Google Scholar] [CrossRef]
- Kainourgios, P.; Tziveleka, L.-A.; Kartsonakis, I.A.; Ioannou, E.; Roussis, V.; Charitidis, C.A. Silver Nanoparticles Grown on Cross-Linked Poly (Methacrylic Acid) Microspheres: Synthesis, Characterization, and Antifungal Activity Evaluation. Chemosensors 2021, 9, 152. [Google Scholar] [CrossRef]
- Almatroudi, A. Silver Nanoparticles: Synthesis, Characterisation and Biomedical Applications. Open Life Sci. 2020, 15, 819–839. [Google Scholar] [CrossRef]
- Vidyasagar; Patel, R.R.; Singh, S.K.; Singh, M. Green Synthesis of Silver Nanoparticles: Methods, Biological Applications, Delivery and Toxicity. Mater. Adv. 2023, 4, 1831–1849. [Google Scholar] [CrossRef]
- Garibo, D.; Borbón-Nuñez, H.A.; de León, J.N.D.; García Mendoza, E.; Estrada, I.; Toledano-Magaña, Y.; Tiznado, H.; Ovalle-Marroquin, M.; Soto-Ramos, A.G.; Blanco, A.; et al. Green Synthesis of Silver Nanoparticles Using Lysiloma Acapulcensis Exhibit High-Antimicrobial Activity. Sci. Rep. 2020, 10, 12805. [Google Scholar] [CrossRef] [PubMed]
- Vijayaram, S.; Razafindralambo, H.; Sun, Y.-Z.; Vasantharaj, S.; Ghafarifarsani, H.; Hoseinifar, S.H.; Raeeszadeh, M. Applications of Green Synthesized Metal Nanoparticles—A Review. Biol. Trace Elem. Res. 2023, 1–27. [Google Scholar] [CrossRef] [PubMed]
- Urnukhsaikhan, E.; Bold, B.-E.; Gunbileg, A.; Sukhbaatar, N.; Mishig-Ochir, T. Antibacterial Activity and Characteristics of Silver Nanoparticles Biosynthesized from Carduus Crispus. Sci. Rep. 2021, 11, 21047. [Google Scholar] [CrossRef]
- Ibrahim, S.; Ahmad, Z.; Manzoor, M.Z.; Mujahid, M.; Faheem, Z.; Adnan, A. Optimization for Biogenic Microbial Synthesis of Silver Nanoparticles through Response Surface Methodology, Characterization, Their Antimicrobial, Antioxidant, and Catalytic Potential. Sci. Rep. 2021, 11, 770. [Google Scholar] [CrossRef]
- Baran, A.; Fırat Baran, M.; Keskin, C.; Hatipoğlu, A.; Yavuz, Ö.; İrtegün Kandemir, S.; Adican, M.T.; Khalilov, R.; Mammadova, A.; Ahmadian, E.; et al. Investigation of Antimicrobial and Cytotoxic Properties and Specification of Silver Nanoparticles (AgNPs) Derived From Cicer arietinum L. Green Leaf Extract. Front. Bioeng. Biotechnol. 2022, 10, 855136. [Google Scholar] [CrossRef]
- Caroline, M.L.; Muthukumar, R.S.; Priya, A.H.H.; Nachiammai, N. Anticancer Effect of Plectranthus Amboinicus and Glycyrrhiza Glabra on Oral Cancer Cell Line: An Invitro Experimental Study. Asian Pacific J. Cancer Prev. 2023, 24, 881–887. [Google Scholar] [CrossRef]
- Stasińska-Jakubas, M.; Hawrylak-Nowak, B.; Wójciak, M.; Dresler, S. Comparative Effects of Two Forms of Chitosan on Selected Phytochemical Properties of Plectranthus amboinicus (Lour.). Molecules 2023, 28, 376. [Google Scholar] [CrossRef]
- Jena, B.; Biswal, B.; Sarangi, A.; Giri, A.K.; Bhattacharya, D.; Acharya, L. GC/MS Profiling and Evaluation of Leaf Essential Oil for Bactericidal Effect and Free Radical Scavenging Activity of Plectranthus Amboinicus (Lour.) Spreng Collected from Odisha, India. Chem. Biodivers. 2023, 20, e202200691. [Google Scholar] [CrossRef]
- Gomathi, A.C.; Xavier Rajarathinam, S.R.; Mohammed Sadiq, A.; Rajeshkumar, S. Anticancer Activity of Silver Nanoparticles Synthesized Using Aqueous Fruit Shell Extract of Tamarindus Indica on MCF-7 Human Breast Cancer Cell Line. J. Drug Deliv. Sci. Technol. 2020, 55, 101376. [Google Scholar] [CrossRef]
- Mustapha, T.; Misni, N.; Ithnin, N.R.; Daskum, A.M.; Unyah, N.Z. A Review on Plants and Microorganisms Mediated Synthesis of Silver Nanoparticles, Role of Plants Metabolites and Applications. Int. J. Environ. Res. Public Health 2022, 19, 674. [Google Scholar] [CrossRef] [PubMed]
- Kumar, L.; Mohan, L.; Anand, R.; Bharadvaja, N. Chlorella Minutissima-Assisted Silver Nanoparticles Synthesis and Evaluation of Its Antibacterial Activity. Syst. Microbiol. Biomanuf. 2023, 1–10. [Google Scholar] [CrossRef]
- Mikhailova, E.O. Silver Nanoparticles: Mechanism of Action and Probable Bio-Application. J. Funct. Biomater. 2020, 11, 84. [Google Scholar] [CrossRef] [PubMed]
- Alahmad, A.; Al-Zereini, W.A.; Hijazin, T.J.; Al-Madanat, O.Y.; Alghoraibi, I.; Al-Qaralleh, O.; Al-Qaraleh, S.; Feldhoff, A.; Walter, J.-G.; Scheper, T. Green Synthesis of Silver Nanoparticles Using Hypericum Perforatum L. Aqueous Extract with the Evaluation of Its Antibacterial Activity against Clinical and Food Pathogens. Pharmaceutics 2022, 14, 1104. [Google Scholar] [CrossRef]
- Hano, C.; Abbasi, B.H. Plant-Based Green Synthesis of Nanoparticles: Production, Characterization and Applications. Biomolecules 2021, 12, 31. [Google Scholar] [CrossRef]
- Bhaskar, S.; Srinivasan, V.; Ramamurthy, S.S. Nd2O3-Ag Nanostructures for Plasmonic Biosensing, Antimicrobial, and Anticancer Applications. ACS Appl. Nano Mater. 2023, 6, 1129–1145. [Google Scholar] [CrossRef]
- Alsareii, S.A.; Manaa Alamri, A.; AlAsmari, M.Y.; Bawahab, M.A.; Mahnashi, M.H.; Shaikh, I.A.; Shettar, A.K.; Hoskeri, J.H.; Kumbar, V. Synthesis and Characterization of Silver Nanoparticles from Rhizophora Apiculata and Studies on Their Wound Healing, Antioxidant, Anti-Inflammatory, and Cytotoxic Activity. Molecules 2022, 27, 6306. [Google Scholar] [CrossRef]
- Naveed, M.; Bukhari, B.; Aziz, T.; Zaib, S.; Mansoor, M.A.; Khan, A.A.; Shahzad, M.; Dablool, A.S.; Alruways, M.W.; Almalki, A.A.; et al. Green Synthesis of Silver Nanoparticles Using the Plant Extract of Acer Oblongifolium and Study of Its Antibacterial and Antiproliferative Activity via Mathematical Approaches. Molecules 2022, 27, 4226. [Google Scholar] [CrossRef]
- Balashanmugam, P.; Pudupalayam Thangavelu, K. Biosynthesis Characterization of Silver Nanoparticles Using Cassia Roxburghii DC. Aqueous Extract, and Coated on Cotton Cloth for Effective Antibacterial Activity. Int. J. Nanomed. 2015, 2015, 87. [Google Scholar] [CrossRef]
- Hemlata; Meena, P.R.; Singh, A.P.; Tejavath, K.K. Biosynthesis of Silver Nanoparticles Using Cucumis Prophetarum Aqueous Leaf Extract and Their Antibacterial and Antiproliferative Activity Against Cancer Cell Lines. ACS Omega 2020, 5, 5520–5528. [Google Scholar] [CrossRef] [PubMed]
- Khan, M.; Karuppiah, P.; Alkhathlan, H.Z.; Kuniyil, M.; Khan, M.; Adil, S.F.; Shaik, M.R. Green Synthesis of Silver Nanoparticles Using Juniperus Procera Extract: Their Characterization, and Biological Activity. Crystals 2022, 12, 420. [Google Scholar] [CrossRef]
- Noorbazargan, H.; Amintehrani, S.; Dolatabadi, A.; Mashayekhi, A.; Khayam, N.; Moulavi, P.; Naghizadeh, M.; Mirzaie, A.; Rad, F.M.; Kavousi, M. Anti-Cancer & Anti-Metastasis Properties of Bioorganic-Capped Silver Nanoparticles Fabricated from Juniperus Chinensis Extract against Lung Cancer Cells. AMB Express 2021, 11, 61. [Google Scholar] [CrossRef] [PubMed]
- Khan, M.S.; Alomari, A.; Tabrez, S.; Hassan, I.; Wahab, R.; Bhat, S.A.; Alafaleq, N.O.; Altwaijry, N.; Shaik, G.M.; Zaidi, S.K.; et al. Anticancer Potential of Biogenic Silver Nanoparticles: A Mechanistic Study. Pharmaceutics 2021, 13, 707. [Google Scholar] [CrossRef]
- Wu, H.; Chen, L.; Zhu, F.; Han, X.; Sun, L.; Chen, K. The Cytotoxicity Effect of Resveratrol: Cell Cycle Arrest and Induced Apoptosis of Breast Cancer 4T1 Cells. Toxins 2019, 11, 731. [Google Scholar] [CrossRef] [PubMed]
Disclaimer/Publisher’s Note: The statements, opinions and data contained in all publications are solely those of the individual author(s) and contributor(s) and not of MDPI and/or the editor(s). MDPI and/or the editor(s) disclaim responsibility for any injury to people or property resulting from any ideas, methods, instructions or products referred to in the content. |
© 2023 by the authors. Licensee MDPI, Basel, Switzerland. This article is an open access article distributed under the terms and conditions of the Creative Commons Attribution (CC BY) license (https://creativecommons.org/licenses/by/4.0/).